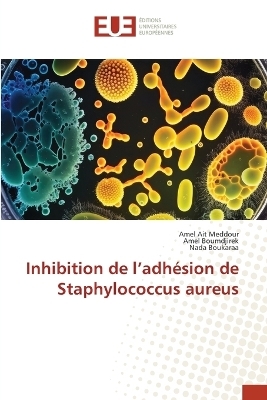
Inhibition de l'adh&eacute;sion de Staphylococcus aureus - Amel Ait Meddour, Amel Boumdjirek, Nada Boukaraa

Inhibition de l'adhésion de Staphylococcus aureus
Seiten
2023
International Book Market Service Ltd (Verlag)
978-620-3-45694-3 (ISBN)
International Book Market Service Ltd (Verlag)
978-620-3-45694-3 (ISBN)
- Keine Verlagsinformationen verfügbar
- Artikel merken
Staphylococcus aureus, un pathogène ayant la capacité de former un biofilm sur les surfaces des équipements, et régulièrement rencontré dans de très nombreux environnements, en particulier ceux de la chaîne alimentaire. Les biofilms staphylococciques fournissent un important facteur de virulence pour ces bactéries et sont particulièrement connus par leurs effets négatifs. Parmi leurs impacts négatifs les plus connus, les contaminations de produits alimentaires ce qui est à l'origine de TIA et la biodeterioration des matériaux. Les bactéries lactiques sont utilisées pour leurs différentes propriétés. Elles ont la capacité de produire lors de leur croissance des composés actifs à savoir les acides organiques, le H2O2, le CO2 et des substances naturelles de nature protéique douées d'activité antagoniste à l'encontre d'un grand nombre de germes pathogènes et d'altération. C'est pour cette raison que ces bactéries et/ou leurs métabolites sont proposés en industries agroalimentaires comme un moyen de lutte contre la formation de biofilms négatifs.
AIT MEDDOUR AmelGrade: Maitre de Conférences-Classe A
| Erscheinungsdatum | 09.06.2023 |
|---|---|
| Verlagsort | Beau Bassin |
| Sprache | französisch |
| Maße | 152 x 229 mm |
| Gewicht | 108 g |
| Themenwelt | Naturwissenschaften ► Biologie ► Allgemeines / Lexika |
| Naturwissenschaften ► Biologie ► Mikrobiologie / Immunologie | |
| Schlagworte | adhésion • bactéries lactiques • biofilms négatifs • inhibition de l'adhésion. • Staphylococcus aureus |
| ISBN-10 | 620-3-45694-2 / 6203456942 |
| ISBN-13 | 978-620-3-45694-3 / 9786203456943 |
| Zustand | Neuware |
| Informationen gemäß Produktsicherheitsverordnung (GPSR) | |
| Haben Sie eine Frage zum Produkt? |
Mehr entdecken
aus dem Bereich
aus dem Bereich
Buch | Softcover (2024)
Wiley-VCH (Verlag)
CHF 55,85
Band 2: Elektrizität, Optik und Wellen
Buch | Softcover (2022)
Wiley-VCH (Verlag)
CHF 55,85
Vom Ursprung der Sexualitat zum modernen Menschen
Buch | Softcover (2025)
UTB (Verlag)
CHF 54,60


